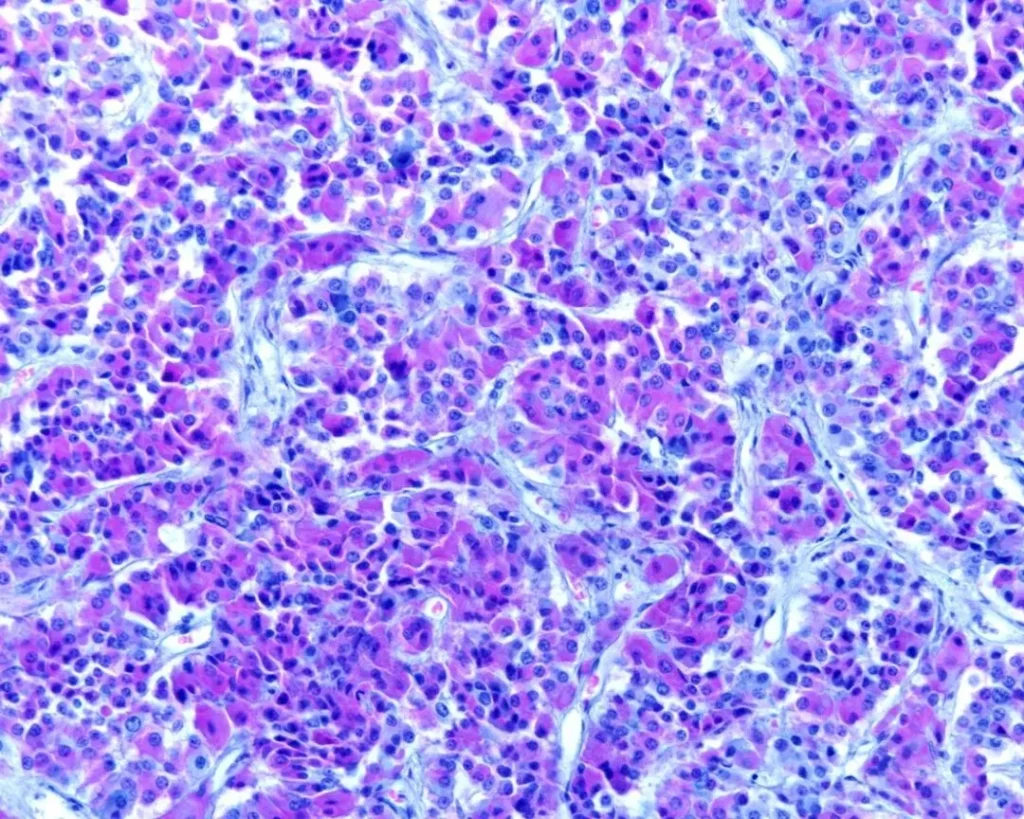

Blogs
Sermorelin & Ipamorelin Blend : The Potential of Anabolism and Synergism
Sermorelin and Ipamorelin Blend are research peptides that may have synergistic actions when blended, as they may stimulate the release of growth hormone (hGH) from pituitary cells via complementary pathways. Sermorelin appears to be analogous to the endogenous GHRH, which may interact with the GHRH receptors on anterior pituitary cells and stimulate hGH release.

The same cells also appear to possess another set of receptors called growth hormone secretagogue receptors 1a (GHS-R1a), and endogenously, the hormone ghrelin may trigger them. Despite sharing no homology with this hormone, the peptide Ipamorelin appears to possess high selectivity towards the GHS-R1a and activate them. Below, we will break down the available laboratory research on whether the combination of Sermorelin and Ipamorelin may stimulate different signaling pathways and thus exert a synergistically higher hGH peak synthesis from pituitary cells than either peptide alone.
Research
Sermorelin & Ipamorelin Structural Differences
Sermorelin is a research peptide that appears to replicate the biologically active N-terminal portion of endogenous growth hormone-releasing hormone, specifically the first 29 amino acids. According to researchers such as Clark et al., this fragment appears to be the shortest GHRH-based sequence that may still retain the ability to interact with GHRH receptors on pituitary somatotroph cells. (1) In other words, the preserved 1-29 sequence is generally considered sufficient to maintain the key binding region of endogenous GHRH needed for receptor recognition and activation while excluding the rest of the full 44-amino acid GHRH molecule.
Sermorlein also appears to be amidated at the C-terminus, which may help support its resistance to enzymatic breakdown and possibly support a more stable conformation in solution during laboratory research. Ipamorelin is also a research peptide, but it significantly differs in terms of structure, and this appears to act through a different receptor system within the same pituitary cell population. Structurally, Ipamorelin is a synthetic pentapeptide composed of Aib-His-D-2-Nal-D-Phe-Lys-NH₂. Mechanistically, researchers such as Raun et al. suggest that Ipamorelin may work as a selective growth hormone secretagogue that may interact with the growth hormone secretagogue receptor, also referred to as GHS-R1a, aka the ghrelin receptor.(2)
Although Ipamorelin appears to stimulate the same endocrine axis as ghrelin, it does not seem to share structural similarity with endogenous ghrelin itself. Instead, researchers present it as a synthetic compound developed from earlier GHRP models, incorporating synthetic D-form amino acid features that may support receptor affinity and selectivity. Unlike other GHRP compounds in this group, Ipamorelin also appears to indicate a relatively narrow receptor profile, with findings drawn from laboratory settings suggesting that it may preferentially activate the hGH synthesis, without supporting any other hormones typically secreted by pituitary cells.
Sermorelin & Ipamorelin Interactions with Pituitary Cells
Research by Halmos et al. suggests Sermorelin may stimulate GHRH receptors in pituitary cells by interacting with the surface of this G-protein-coupled receptor in a way that appears to stabilize its active form and favor coupling to G-protein α subunit.(3) The G protein of the GHRH receptor is generally described as a membrane-linked signaling switch that may transmit receptor activation to downstream intracellular enzymes. Once this coupling occurs, Sermorelin appears to activate adenylyl cyclase and raise intracellular cyclic AMP, which appears to function as a key second messenger in pituitary cell signaling. The increase in cAMP may then activate an enzyme that seems to regulate downstream proteins through phosphorylation called protein kinase A.
The research of Takei et al. suggests that the GHRH receptor activation also appears capable of promoting depolarizing cation currents, which may help open voltage-dependent calcium channels.(4) The resulting rise in intracellular Ca²⁺ in combination with the activated cAMP pathway is thought to serve as a direct trigger for exocytosis of growth hormone-containing granules.
Ipamorelin appears to engage the same endocrine output through a different receptor pathway. Rather than acting at the GHRH receptor, it seems to bind selectively to GHS-R1a and may preferentially couple this receptor to Gq/11 proteins. This interaction is thought to activate phospholipase C, which may then split membrane phospholipids into two signaling molecules. Specifically, those are the secondary messengers Inositol trisphosphate (IP₃) and Diacylglycerol (DAG). IP₃ appears to promote the release of Ca²⁺ from intracellular stores, while DAG may stimulate protein kinase C (PKC). Together, the rise in cytosolic calcium and PKC activity may support exocytosis of stored growth hormone from pituitary cells.
The aforementioned laboratory experiments by Raun et al. also suggest that Ipamorelin may be unusually selective among growth hormone secretagogues.(2) The peptide may act strongly at the GH axis of pituitary cells while indicating little or no meaningful activity on other pituitary cell hormones such as FSH, LH, prolactin, or TSH. Raun et al. also commented that apparently “Ipamorelin did not release ACTH or cortisol in levels significantly different from those observed following GHRH stimulation”. Thus, Ipamorelin may often be regarded as a particularly selective tool for growth hormone-related research in mammalian cell models.
Sermorelin & Ipamorelin Anabolic Potential
Laboratory findings from pituitary-based models suggest that by activating the GHRH receptors, Sermorelin may increase growth hormone output from somatotroph cells. However, the magnitude of this response appears to differ across laboratory settings. In the work described by Vittone et al., mean growth hormone concentrations measured over 12 hours were reported to rise from about 1.1 ± 0.9 µg/L to approximately 2.2 ± 1.9 µg/L, which is consistent with roughly a twofold increase.(5)
Yet, other researchers suggest that while the 12-hour average levels may double, the actual peak synthesis is limited to the first 2 hours after Sermolrelin exposure. Notably, Khorram et al. suggest that the increase in hGH output may cluster within the first two hours.(6) In that setting, the study authors described the integrated hGH response over two hours as increasing from roughly 200 to 300 µg·L⁻¹·min at baseline to around 1,100 to 1,600 µg·L⁻¹·min after exposure, which corresponds to an increase of about fivefold to sixfold. The same work also suggests that these relatively short hGH pulses may be sufficient to increase downstream IGF-1 production in responsive systems. IGF-1 is considered the main anabolic mediator of hGH. More specifically, the rise in hGH appeared to coincide with an up to 28% increase in IGF-1.Sermorelin & Ipamorelin Blend
According to Gobburu et al., Ipamorelin has also been reported to induce marked hGH release in laboratory models, in some cases with greater peak amplitude than that described for Sermorelin alone.(7) Research discussed by Gobburu et al. suggests that Ipamorelin may increase growth hormone concentrations to around 80 mIU/L, or roughly 27 ng/mL, when acting through growth hormone secretagogue receptors in pituitary tissue. This may be presented as approximately 2-5x times higher than commonly referenced physiological peak values in mammalian models. Such peaks may also induce anabolic signaling by triggering downstream IGF-1 synthesis.
Beyond the anabolic signaling via pituitary cells, Ipamorelin may also interact with other ghrelin-responsive nerve cells. This is important because ghrelin signaling may be closely tied not only to growth hormone release but also to hunger hormone regulation. Experimental observations such as those reported by Lall et al. suggest that this broader receptor activity may contribute to increases in research models’ total weight, with reported gains exceeding 15%.(8) These actions may not be explained by anabolic signaling alone and may partly reflect stronger hunger hormone-related signaling triggered through ghrelin receptor activation. Sermorelin & Ipamorelin Blend
Sermorelin & Ipamorelin Synergistic Potential
When the GHRH receptor pathway and the GHS-R1a pathway are stimulated at the same time, experimental findings suggest that pituitary growth hormone output may rise above the level produced by either signaling route on its own. At present, there do not appear to be laboratory studies that have evaluated this exact type of dual exposure using Sermorelin together with Ipamorelin, or either of the peptides in a comparable combination.
Even so, the available data appear to support the idea of additive or possibly synergistic signaling. In the work discussed by Veldhuis et al., a Sermorelin-like (full-length GHRH) compound analogous to Sermorelin and a secretagogue (GHS) comparable to Ipamorelin may have indicated synergistic actions.(9) In that dataset, the GHRH analogue was associated with an approximately 20-fold rise over saline, while the GHS produced an increase of roughly 47-fold. When both were applied together, however, the response reportedly increased to around 54-fold. This pattern is compatible with the possibility that simultaneous stimulation of both receptor systems may amplify pituitary signaling beyond the independent contribution of each pathway. Sermorelin & Ipamorelin Blend
A similar finding was described by Cordido et al., who evaluated another GHS-related compound with the full-length GHRH.(10) The researchers commented that their “data [may indicate] that GH responses to [the GHS] were almost twice those to GHRH”. Specifically, the GHS-related compound appears to have generated a peak growth hormone response of about 6 mU/L, whereas the GHRH analogue produced a smaller peak of around 2.6 mU/L. Yet when both agents were studied together, the peak reportedly rose to approximately 16.3 mU/L. Sermorelin & Ipamorelin Blend
The longer 12-hour exposure data appear to point in the same direction. The authors reported integrated growth hormone output of about 260 mU·min/L with the GHS alone and roughly 159 mU·min/L with the GHRH alone, but increased to nearly 729 mU·min/L under combined evaluation. Taken together, these findings suggest that a blend such as Sermorelin and Ipamorelin may potentially engage complementary or synergistic pituitary mechanisms and produce a greater secretory response than either peptide alone.
NOTE: These products are intended for laboratory research use only. This peptide is not intended for personal use. Please review and adhere to our Terms and Conditions before ordering. Sermorelin & Ipamorelin Blend
References:
- Clark RG, Robinson IC. Growth induced by pulsatile infusion of an amidated fragment of hGH-releasing factor in normal and GHRF-deficient rats. Nature. 1985 Mar 21-27;314(6008):281-3. doi: 10.1038/314281a0. PMID: 2858818.
- Raun K, Hansen BS, Johansen NL, Thøgersen H, Madsen K, Ankersen M, Andersen PH. Ipamorelin, the first selective growth hormone secretagogue. Eur J Endocrinol. 1998 Nov;139(5):552-61. doi: 10.1530/eje.0.1390552. PMID: 9849822.
- Halmos G, Szabo Z, Dobos N, Juhasz E, Schally AV. Growth hormone-releasing hormone receptor (GHRH-R) and its signaling. Rev Endocr Metab Disord. 2025 Jun;26(3):343-352. doi: 10.1007/s11154-025-09952-x. Epub 2025 Feb 12. PMID: 39934495; PMCID: PMC12137518.
- Takei T, Yasufuku-Takano J, Takano K, Fujita T, Yamashita N. Effect of Ca2+ and cAMP on capacitance-measured hormone secretion in human GH-secreting adenoma cells. Am J Physiol. 1998 Oct;275(4):E649-54. doi: 10.1152/ajpendo.1998.275.4.E649. PMID: 9755084.
- Gobburu, J. V., Agersø, H., Jusko, W. J., & Ynddal, L. (1999). Pharmacokinetic-pharmacodynamic modeling of ipamorelin, a growth hormone releasing peptide. Pharmaceutical research, 16(9), 1412–1416. https://doi.org/10.1023/a:1018955126402
- Khorram O, Laughlin GA, Yen SS. Endocrine and metabolic effects of long-term administration of [Nle27]growth hormone-releasing hormone-(1-29)-NH2 in age-advanced men and women. J Clin Endocrinol Metab. 1997 May;82(5):1472-9. doi: 10.1210/jcem.82.5.3943. PMID: 9141536.
- Gobburu, J. V., Agersø, H., Jusko, W. J., & Ynddal, L. (1999). Pharmacokinetic-pharmacodynamic modeling of ipamorelin, a growth hormone releasing peptide. Pharmaceutical research, 16(9), 1412–1416. https://doi.org/10.1023/a:1018955126402
- Lall, S., Tung, L. Y., Ohlsson, C., Jansson, J. O., & Dickson, S. L. (2001). Growth hormone (GH)-independent stimulation of adiposity by GH secretagogues. Biochemical and biophysical research communications, 280(1), 132–138. https://doi.org/10.1006/bbrc.2000.4065
- Veldhuis JD, Keenan DM. Secretagogues govern GH secretory-burst waveform and mass in healthy eugonadal and short-term hypogonadal men. Eur J Endocrinol. 2008 Nov;159(5):547-54. doi: 10.1530/EJE-08-0414. Epub 2008 Aug 14. Erratum in: Eur J Endocrinol. 2008 Dec;159(6):841. PMID: 18703567; PMCID: PMC2680123.
- Cordido F, Peñalva A, Dieguez C, Casanueva FF. Massive growth hormone (GH) discharge in obese subjects after the combined administration of GH-releasing hormone and GHRP-6: evidence for a marked somatotroph secretory capability in obesity. J Clin Endocrinol Metab. 1993 Apr;76(4):819-23. doi: 10.1210/jcem.76.4.8473389. PMID: 8473389.